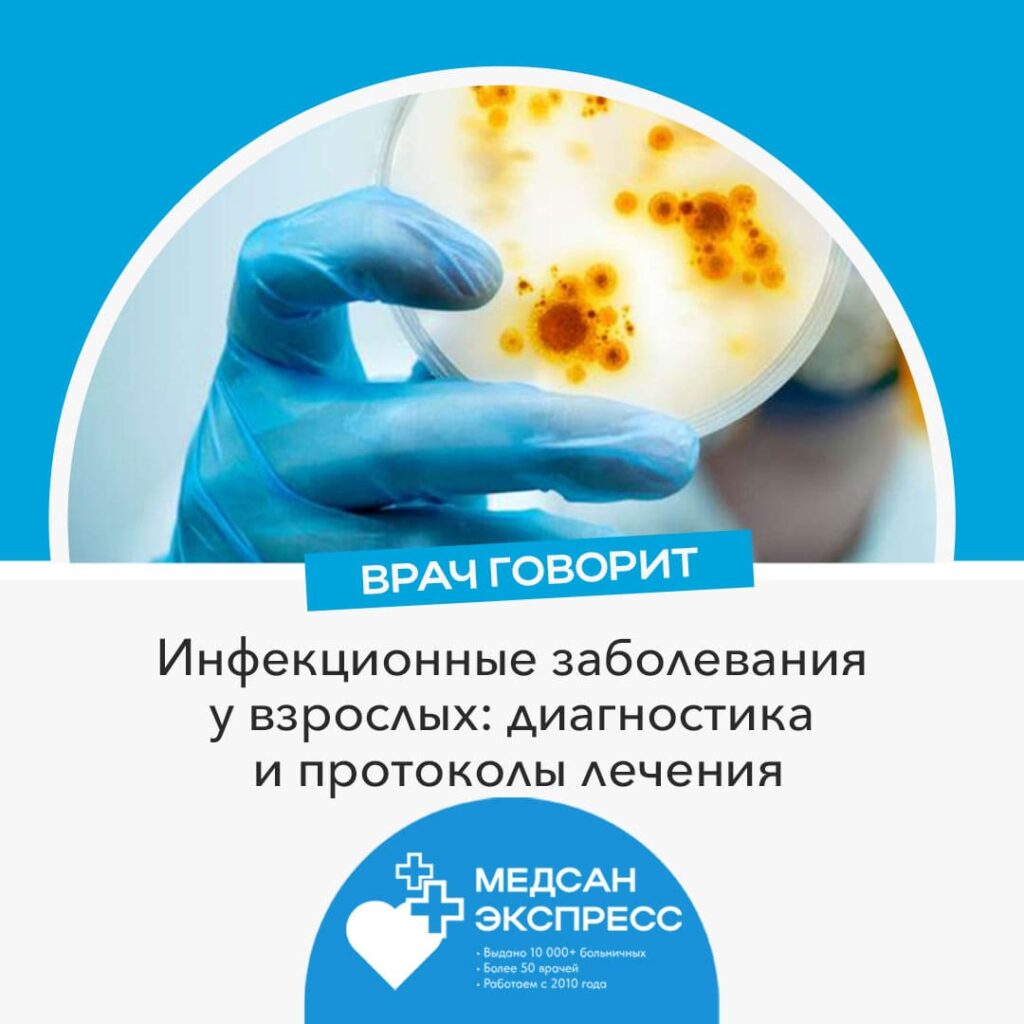

👩🏼⚕️ Лицензия Л041-01137-77/00367811
Работаем с 7:00 до 23:00
Работаем с 7:00 до 23:00
- Главная
- О центре
- Больничные листы
- Больничный при артрите
- Больничный при беременности
- Больничный при бронхите
- Больничный при боли в горле
- Больничный при ветрянке
- Больничный при гриппе
- Больничный при грыже
- Больничный при боли COVID-19
- Больничный при миоме матки
- Больничный при ОРВИ
- Больничный при отравлении
- Больничный при переломе ноги
- Больничный при переломе руки
- Больничный при пневмонии
- Больничный при растяжении
- Больничный при родах
- Больничный при сотрясении мозга
- Больничный при ушибе
- Больничный по уходу за ребенком до 7 лет
- Больничный по уходу за ребенком от 7-15 лет
- Адреса мед. центров
- Цены на услуги
- Контакты
Работаем с 7:00 до 23:00
- Главная
- О центре
- Больничные листы
- Больничный при артрите
- Больничный при беременности
- Больничный при бронхите
- Больничный при боли в горле
- Больничный при ветрянке
- Больничный при гриппе
- Больничный при грыже
- Больничный при боли COVID-19
- Больничный при миоме матки
- Больничный при ОРВИ
- Больничный при отравлении
- Больничный при переломе ноги
- Больничный при переломе руки
- Больничный при пневмонии
- Больничный при растяжении
- Больничный при родах
- Больничный при сотрясении мозга
- Больничный при ушибе
- Больничный по уходу за ребенком до 7 лет
- Больничный по уходу за ребенком от 7-15 лет
- Адреса мед. центров
- Цены на услуги
- Контакты
Сноска об авторе статьи:
«Материал подготовлен врачом-инфекционистом высшей категории МедСан Экспресс Соколовой Инной Юрьевной. Более 16 лет практики в области инфекционных заболеваний, специализируется на диагностике и лечении вирусных и бактериальных инфекций. Постоянно совершенствует свои знания в области современных методов диагностики и лечения инфекционных заболеваний, участвует в научных конференциях и семинарах по инфектологии.»
Инфекционные заболевания требуют особого внимания и своевременного начала лечения. Как врач-инфекционист МедСан Экспресс, хочу поделиться современными подходами к диагностике и лечению наиболее распространенных инфекционных заболеваний у взрослых.
Современная диагностика
В МедСан Экспресс мы используем комплексный подход к диагностике инфекционных заболеваний, включающий как классические, так и современные методы исследования. Первичная диагностика начинается с тщательного сбора анамнеза и осмотра пациента.
Основные диагностические методы:
- Лабораторные исследования крови
- ПЦР-диагностика
- Бактериологические посевы
- Иммуноферментный анализ
- Экспресс-тесты для определения возбудителей
- Серологические исследования
Наиболее частые инфекционные заболевания
В нашей практике мы регулярно сталкиваемся со следующими заболеваниями:
Острые кишечные инфекции:
- Сальмонеллез
- Ротавирусная инфекция
- Пищевые токсикоинфекции
- Дизентерия
Воздушно-капельные инфекции:
Современные протоколы лечения
Лечение инфекционных заболеваний строится на нескольких принципах:
- Этиотропная терапия:
- Противовирусные препараты
- Антибактериальные средства
- Противогрибковые препараты
- Патогенетическая терапия:
- Дезинтоксикационная терапия
- Восстановление водно-электролитного баланса
- Иммуномодулирующая терапия при необходимости
- Симптоматическое лечение:
- Жаропонижающие средства
- Противорвотные препараты
- Спазмолитики
Особенности оформления больничного листа
При инфекционных заболеваниях сроки временной нетрудоспособности определяются индивидуально, учитывая:
- Тяжесть заболевания
- Наличие осложнений
- Период заразности для окружающих
- Скорость восстановления
Профилактика и предупреждение распространения
Ключевые меры профилактики инфекционных заболеваний:
- Соблюдение правил личной гигиены
- Своевременная вакцинация
- Изоляция заболевших
- Правильная термическая обработка продуктов
- Использование средств индивидуальной защиты при необходимости
Когда срочно обращаться к врачу
Симптомы, требующие немедленного обращения к инфекционисту:
- Высокая температура (выше 38,5°C), не снижающаяся жаропонижающими
- Сильная головная боль с рвотой
- Появление сыпи
- Выраженная интоксикация
- Обезвоживание
- Нарушение сознания
Инфекционные заболевания требуют грамотного подхода к диагностике и лечению. В МедСан Экспресс мы обеспечиваем полный комплекс медицинской помощи, от первичной диагностики до полного выздоровления пациента. Важно помнить, что своевременное обращение к специалисту и точное соблюдение назначений врача – ключевые факторы успешного лечения инфекционных заболеваний.






